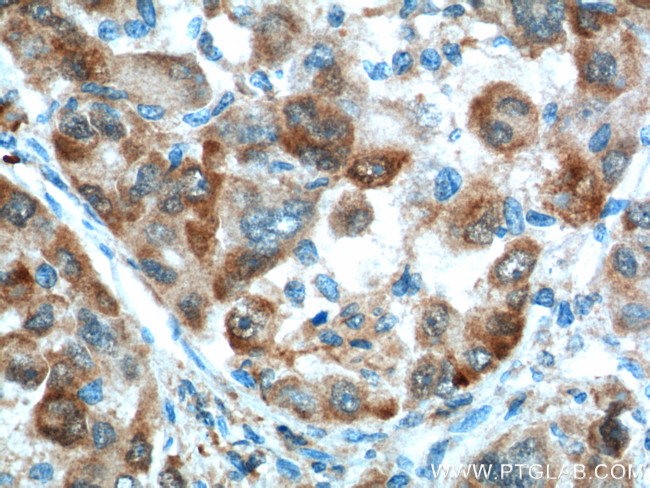
Glutamine synthetase Antibody in Immunohistochemistry (Paraffin) (IHC (P))

Search
Proteintech
Glutamine synthetase Monoclonal Antibody (1D10G8)
{{$productOrderCtrl.translations['antibody.pdp.commerceCard.promotion.promotions']}}
{{$productOrderCtrl.translations['antibody.pdp.commerceCard.promotion.viewpromo']}}
{{$productOrderCtrl.translations['antibody.pdp.commerceCard.promotion.promocode']}}: {{promo.promoCode}} {{promo.promoTitle}} {{promo.promoDescription}}. {{$productOrderCtrl.translations['antibody.pdp.commerceCard.promotion.learnmore']}}
产品信息
66323-1-IG
种属反应
宿主/亚型
分类
类型
克隆号
抗原
偶联物
形式
浓度
规格
纯化类型
保存液
内含物
保存条件
运输条件
产品详细信息
Immunogen sequence: MTTSASSHL NKGIKQVYMS LPQGEKVQAM YIWIDGTGEG LRCKTRTLDS EPKCVEELPE WNFDGSSTLQ SEGSNSDMYL VPAAMFRDPF RKDPNKLVLC EVFKYNRRPA ETNLRHTCKR IMDMVSNQHP WFGMEQEYTL MGTDGHPFGW PSNGFPGPQG PYYCGVGADR AYGRDIVEAH YRACLYAGVK IAGTNAEVMP AQWEFQIGPC EGISMGDHLW VARFILHRVC EDFGVIATFD PKPIPGNWNG AGCHTNFSTK AMREENGLKY IEEAIEKLSK RHQYHIRAYD PKGGLDNARR LTGFHETSNI NDFSAGVANR SASIRIPRTV GQEKKGYFED RRPSANCDPF SVTEALIRTC LLNETGDEPF QYKN (1-373 aa encoded by BC011700)
靶标信息
Glutamine synthase is part of the glutamine synthetase family. Ammonia incorporation in animals occurs through the actions of glutamate dehydrogenase and glutamine synthase. Glutamate plays the central role in mammalian nitrogen flow, serving as both a nitrogen donor and nitrogen acceptor. It also has an important role in controlling metabolic regulations of neurotransmitter glutamate. Because of the multiple functions and importance of GS in cellular metabolism, both catalytic activities and synthesis are highly regulated. The activity of GS is controlled by adenylylation. Its activity is decreased in the cerebral cortex of brains affected by Alzheimer's disease, particularly in the vicinity of senile plaques. It is also decreased under conditions of glucose deprivation.
仅用于科研。不用于诊断过程。未经明确授权不得转售。
生物信息学
蛋白别名: cell proliferation-inducing protein 59; GLNA; Glutamate ammonia ligase; glutamate decarboxylase; Glutamate--ammonia ligase; glutamate-ammonia ligase; glutamate-ammonia ligase (glutamine synthetase); glutamine synthase; Glutamine synthetase; glutamine synthetase I; GS; Palmitoyltransferase GLUL; Proliferation inducing protein 43; proliferation-inducing protein 43; unnamed protein product
基因别名: DEE116; GLNS; GLUL; GS; PIG43; PIG59
UniProt ID: (Human) P15104, (Pig) P46410
Entrez Gene ID: (Human) 2752, (Pig) 396944